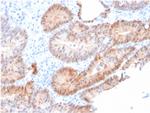
Aldo-keto Reductase Family 1 Member C2/DD2 Antibody in Immunohistochemistry (Paraffin) (IHC (P))

Search
NeoBiotechnologies
Aldo-keto Reductase Family 1 Member C2/DD2 Monoclonal Antibody (CPTC-AKR1C2-1)
{{$productOrderCtrl.translations['antibody.pdp.commerceCard.promotion.promotions']}}
{{$productOrderCtrl.translations['antibody.pdp.commerceCard.promotion.viewpromo']}}
{{$productOrderCtrl.translations['antibody.pdp.commerceCard.promotion.promocode']}}: {{promo.promoCode}} {{promo.promoTitle}} {{promo.promoDescription}}. {{$productOrderCtrl.translations['antibody.pdp.commerceCard.promotion.learnmore']}}
图: 1 / 5
Aldo-keto Reductase Family 1 Member C2/DD2 Antibody (1646-MSM1-P1ABX) in IHC (P)

产品信息
1646-MSM1-P1ABX
种属反应
宿主/亚型
分类
类型
克隆号
抗原
偶联物
形式
浓度
规格
纯化类型
保存液
内含物
保存条件
运输条件
产品详细信息
Immunohistochemistry (PFA fixed): incubate antibody for 30 min RT. Staining of formalin-fixed tissues requires heating tissue sections in 10mM Tris with 1mM EDTA, pH 9.0, for 45 min at 95 degrees C followed by cooling at RT for 20 minutes.
靶标信息
DD1 is also designated AKR1C1, DDH or DDH1, while DD2 also can be designated AKR1C2, dDD, BABP or DDH2. AKR1C3 and 3 alpha-HSD are alternate designations for human DD3 (which is referred to as AKR1C18 in rodents), while DD4 also can be called AKR1C4, CD, CHDR or AKR1C6 (in rodents). DD1 and DD2 are 20 alpha-HSDs, whereas DD3 and DD4 are the 3 alpha- HSDs. The multiple human cytosolic dihydrodiol dehydrogenases are involved in the metabolism of xenobiotics, such as polycyclic aromatic hydrocarbons, pesticides and steroid hormones, and are responsible for the reduction of ketone-containing drugs by using NADH or NADPH as a cofactor. The 20 alpha- HSD catalyzes the reaction of Progesterone to the inactive form 20 alpha-hydroxyprogesterone.
仅用于科研。不用于诊断过程。未经明确授权不得转售。
篇参考文献 (0)
生物信息学
蛋白别名: 3 alpha-HSD3; 3-alpha-HSD3; Aldo-keto reductase family 1 member C2; chlordecone reductase homolog; Chlordecone reductase homolog HAKRD; DD-2; DD/BABP; Dihydrodiol dehydrogenase 2; dihydrodiol dehydrogenase 2; bile acid binding protein; 3-alpha hydroxysteroid dehydrogenase, type III; Dihydrodiol dehydrogenase/bile acid-binding protein; HSD3-3 alpha; HSD3-alpha3; pseudo-chlordecone reductase; testicular 17,20-desmolase deficiency; trans-1,2-dihydrobenzene-1,2-diol dehydrogenase; type II dihydrodiol dehydrogenase; Type III 3-alpha-hydroxysteroid dehydrogenase; unnamed protein product
基因别名: AKR1C-pseudo; AKR1C2; BABP; DD; DD-2; DD/BABP; DD2; DDH2; HAKRD; HBAB; MCDR2; SRXY8; TDD
UniProt ID: (Human) P52895
Entrez Gene ID: (Human) 1646




